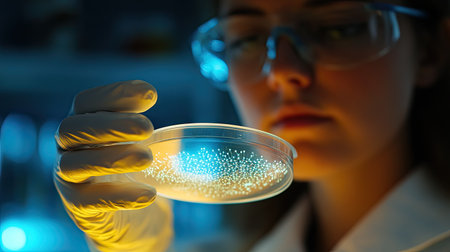
Scientist holding a petri dish with holographic DNA strands floating above, symbolizing gene editingの素材

素材 - Scientist holding a petri dish with holographic DNA strands floating above, symbolizing gene editing
作品情報
Scientist holding a petri dish with holographic DNA strands floating above, symbolizing gene editing
- ID:261368974
- 作品種別:
- 作者名:suphauarrn Manosri
キーワード
- adult
- analyzing
- bacterium
- berlin
- biology
- biotechnology
- chemist
- chemistry
- close-up
- closing
- color image
- doctor
- epidemic
- equipment
- examining
- expertise
- females
- germany
- healthcare and medicine
- holding
- horizontal
- human hand
- humor
- hygiene
- illness
- laboratory
- looking
- males
- medicine
- microbiology
- mid adult
- one person
- people
- pink color
- pipette
- pollution
- portrait
- protection
- quarantine
- research
- science
- scientist
- security
- spain
- technician
- technology
- virus
- white background
類似作品
Portrait of a m...
Elegant waiters...
Male doctor ana...
Scientist exami...
Professional wa...
Hand in blue gl...
Formal service ...
a scientist is ...
Talented chef i...
Waiter with a w...
Nurse carefully...
woman biologist...
Team Asian scie...
Making new disc...
Waiter's hand w...
scientist in a ...
A veterinarian ...
Focused scienti...
Female doctor h...
Chemical Labora...
Woman holding b...
Close up image ...
Hands with a wh...
Scientist pipet...
Chemical Labora...
A scientist in ...
Young businessm...
a doctor or res...
The female doct...
satellite dish ...
plate in hand
A cleaner holds...
Young woman sci...
A microbiologis...
Portrait of a m...
scientist in a ...
Food safety ins...
A group of scie...
Medicine, scien...
Laboratory tech...
Close up of a f...
Young waiter se...
Senior scientis...
Preparing food ...
Chemical Labora...
Upscaled with G...
Hand in blue gl...
Chemical Labora...
Examining woode...